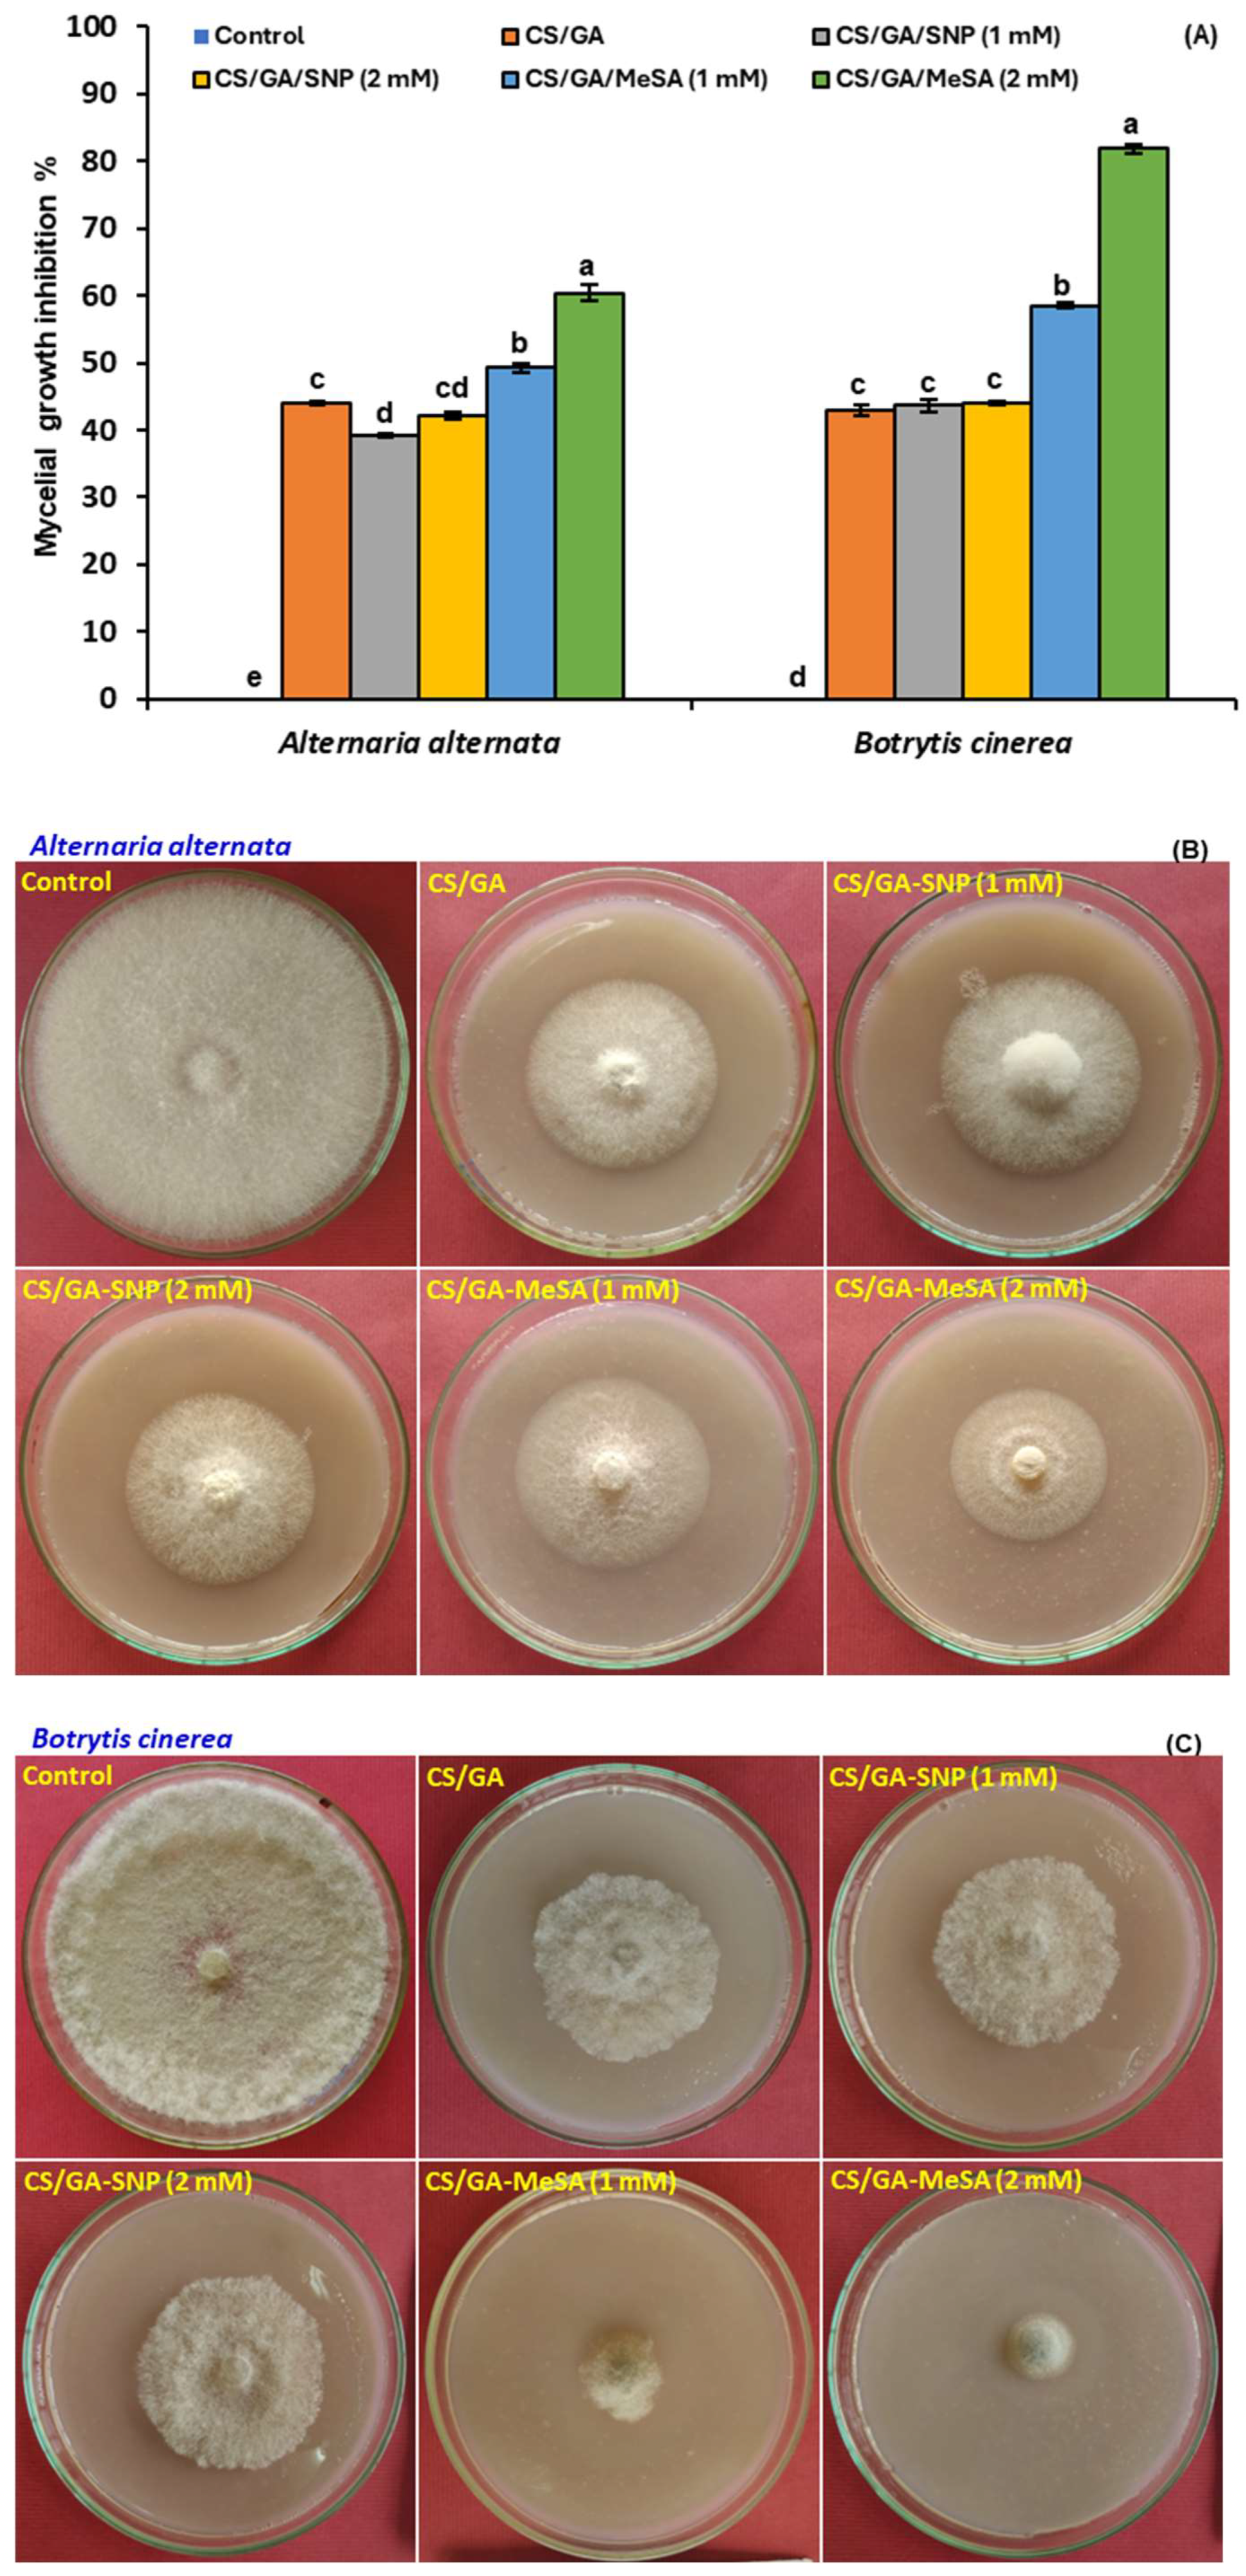
Polymers 16 01518 g004

Effect of Chitosan/Gum Arabic Blends Enriched by Sodium Nitroprusside or Methyl Salicylate on the Storability and Antioxidant Activity of Tomato Fruit
Abstract
1. Introduction
2. Materials and Methods
2.1. Chemicals
2.2. Tomatoes
2.3. Polymers Solutions
2.4. Characterization of Tested Films
2.4.1. Preparation of Coating Films
2.4.2. Attenuated Total-Reflectance Fourier-Transform Infrared Analysis (ATR-FTIR)
2.5. Antifungal Activity
2.6. Transmission Electron Microscope (TEM)
2.7. Treatment of Tomato Fruits
2.8. Physical and Chemical Properties
2.8.1. Fruit Firmness and Titratable Acidity
2.8.2. Analysis of Fruit Pigments
2.8.3. Determination of Non-Enzymatic Antioxidants
2.9. Lipid Peroxidation
2.10. Activity of Antioxidant Enzymes
2.11. Activity of Browning Enzymes
2.12. Statistical Analysis
3. Results and Discussion
3.1. Fourier-Transform Infrared Analysis (FTIR)
3.2. In Vitro Release of NO from CS/GA-SNP Blends
3.3. Antifungal Activity
3.4. Transmission Electron Microscope (TEM)
3.5. Physiochemical Changes during Shelf Life
3.5.1. Fruit Firmness
3.5.2. Titratable Acidity
3.5.3. Total Carotenoids
3.5.4. Lycopene Content
3.5.5. Ascorbic Acid Content
3.5.6. Total Polyphenols
3.5.7. Malondialdehyde (MDA)
3.6. Antioxidant and Browning Enzymes
4. Conclusions
Author Contributions
Funding
Institutional Review Board Statement
Data Availability Statement
Conflicts of Interest
References
- Akrami, M.; Mutlum, C.D.; Javadi, A.A.; Salah, A.H.; Fath, H.E.S.; Dibaj, M.; Farmani, R.; Mohammed, R.H.; Negm, A. Analysis of Inlet Configurations on the Microclimate Conditions of a Novel Standalone Agricultural Greenhouse for Egypt Using Computational Fluid Dynamics. Sustainability 2021, 13, 1446. [Google Scholar] [CrossRef]
- Abdrabbo, M.; Negm, A.; Fath, H.E.; Javadi, A. Greenhouse management and best practice in Egypt. Int. Water Technol. Assoc. 2019, 9, 118–201. [Google Scholar]
- Hassan, G.E.; Salah, A.H.; Fath, H.; Elhelw, M.; Hassan, A.; Saqr, K.M. Optimum operational performance of a new stand-alone agricultural greenhouse with integrated-TPV solar panels. Sol. Energy 2016, 136, 303–316. [Google Scholar] [CrossRef]
- Taher, M.A.; MennatAllah, E.A.; Tadros, L.K.; Sanad, M.I. The effects of new formulations based on Gum Arabic on antioxidant capacity of tomato (Solanum lycopersicum L.) fruit during storage. J. Food Meas. Charact. 2020, 14, 2489–2502. [Google Scholar] [CrossRef]
- Karpova, N.; Shagdarova, B.; Lunkov, A.; Ilina, A.; Varlamov, V. Antifungal action of chitosan in combination with fungicides in vitro and chitosan conjugate with gallic acid on tomatoes against Botrytis cinerea. Biotechnol. Lett. 2021, 43, 1565–1574. [Google Scholar] [CrossRef] [PubMed]
- Elsherbiny, E.A.; Taher, M.A.; Abd El-Aziz, M.H.; Mohamed, S.Y. Action mechanisms and biocontrol of Purpureocillium lilacinum against green mould caused by Penicillium digitatum in orange fruit. J. Appl. Microbiol. 2021, 131, 1378–1390. [Google Scholar] [CrossRef]
- Taher, M.A.; Elsherbiny, E.A. Impact of isonicotinic acid blending in chitosan/polyvinyl alcohol on ripening-dependent changes of green stage tomato. Polymers 2023, 15, 825. [Google Scholar] [CrossRef]
- Lo’ay, A.A.; Dawood, H.D. Active chitosan/PVA with ascorbic acid and berry quality of ‘Superior seedless’ grapes. Sci. Hortic. 2017, 224, 286–292. [Google Scholar] [CrossRef]
- Davidson, E.; Pereira, J.; Gan Giannelli, G.; Murphy, Z.; Anagnostopoulos, V.; Santra, S. Multi-Functional Chitosan Nanovesicles Loaded with Bioactive Manganese for Potential Wound Healing Applications. Molecules 2023, 28, 6098. [Google Scholar] [CrossRef]
- Mestre-Tomás, J.; Esgueva-Vilà, D.; Fuster-Alonso, A.; Lopez-Moya, F.; Lopez-Llorca, L.V. Chitosan modulates volatile organic compound emission from the biocontrol fungus Pochonia chlamydosporia. Molecules 2023, 28, 4053. [Google Scholar] [CrossRef]
- Kritchenkov, A.S.; Egorov, A.R.; Volkova, O.V.; Artemjev, A.A.; Kurliuk, A.V.; Anh, L.T.; Hieu Truong, H.; Le-Nhat-Thuy, G.; Van Tran, T.T.; Van Tuyen, N.; et al. Novel biopolymer-based nanocomposite food coatings that exhibit active and smart properties due to a single type of nanoparticles. Food Chem. 2021, 343, 128676. [Google Scholar] [CrossRef] [PubMed]
- Zhu, Y.; Li, D.; Belwal, T.; Li, L.; Chen, H.; Xu, T.; Luo, Z. Effect of nano-SiOx/chitosan complex coating on the physicochemical characteristics and preservation performance of green tomato. Molecules 2019, 24, 4552. [Google Scholar] [CrossRef] [PubMed]
- Klein, M.; Aserin, A.; Ishai, P.B.; Garti, N. Interactions between whey protein isolate and gum Arabic. Colloids Surf. B Biointerfaces 2010, 79, 377–383. [Google Scholar] [CrossRef] [PubMed]
- Taher, M.A.; Lo’ay, A.A.; Gouda, M.; Limam, S.A.; Abdelkader, M.F.M.; Osman, S.O.; Fikry, M.; Ali, E.F.; Mohamed, S.Y.; Khalil, H.A.; et al. Impacts of Gum Arabic and polyvinylpyrrolidone (PVP) with salicylic acid on peach fruit (Prunus persica) shelf life. Molecules 2022, 27, 2595. [Google Scholar] [CrossRef] [PubMed]
- Kawhena, T.G.; Opara, U.L.; Fawole, O.A. Effect of Gum Arabic and starch-based coating and different polyliners on postharvest quality attributes of whole pomegranate fruit. Processes 2022, 10, 164. [Google Scholar] [CrossRef]
- Morodi, V.; Kaseke, T.; Fawole, O.A. Impact of Gum Arabic coating pretreatment on quality attributes of oven-dried red raspberry (Rubus idaeus L.) Fruit. Processes 2022, 10, 1629. [Google Scholar] [CrossRef]
- El-Gioushy, S.F.; Abdelkader, M.F.M.; Mahmoud, M.H.; Abou El Ghit, H.M.; Fikry, M.; Bahloul, A.M.E.; Morsy, A.R.; A., L.A.; Abdelaziz, A.M.R.A.; Alhaithloul, H.A.S.; et al. The Effects of a Gum Arabic-Based Edible Coating on Guava Fruit Characteristics during Storage. Coatings 2022, 12, 90. [Google Scholar] [CrossRef]
- Maqbool, M.; Ali, A.; Alderson, P.G.; Zahid, N.; Siddiqui, Y. Effect of a novel edible composite coating based on Gum Arabic and chitosan on biochemical and physiological responses of banana fruits during cold storage. J. Agric. Food Chem. 2011, 59, 5474–5482. [Google Scholar] [CrossRef] [PubMed]
- Xu, T.; Gao, C.; Feng, X.; Huang, M.; Yang, Y.; Shen, X.; Tang, X. Cinnamon and clove essential oils to improve physical, thermal and antimicrobial properties of chitosan-gum Arabic polyelectrolyte complexed films. Carbohydr. Polym. 2019, 217, 116–125. [Google Scholar] [CrossRef]
- Zhao, R.; Chen, J.; Yu, S.; Niu, R.; Yang, Z.; Wang, H.; Cheng, H.; Ye, X.; Liu, D.; Wang, W. Active chitosan/gum Arabic-based emulsion films reinforced with thyme oil encapsulating blood orange anthocyanins: Improving multi-functionality. Food Hydrocoll. 2023, 134, 108094. [Google Scholar] [CrossRef]
- Kumar, D. Salicylic acid signaling in disease resistance. Plant Sci. 2014, 228, 127–134. [Google Scholar] [CrossRef] [PubMed]
- García-Pastor, M.E.; Zapata, P.J.; Castillo, S.; Martínez-Romero, D.; Valero, D.; Serrano, M.; Guillén, F. Preharvest salicylate treatments enhance antioxidant compounds, color and crop yield in low pigmented-table grape cultivars and preserve quality traits during storage. Antioxidants 2020, 9, 832. [Google Scholar] [CrossRef]
- Glowacz, M.; Ree, D. Using jasmonates and salicylates to reduce losses within the fruit supply chain. Eur. Food Res. Technol. 2015, 242, 143–156. [Google Scholar] [CrossRef]
- Ali, J.; Wei, D.; Mahamood, M.; Zhou, F.; King, P.J.H.; Zhou, W.; Shamsi, I.H. Exogenous application of methyl salicylate induces defense in Brassica against peach potato aphid Myzus persicae. Plants 2023, 12, 1770. [Google Scholar] [CrossRef]
- Chaudhari, A.K.; Singh, V.K.; Kedia, A.; Das, S.; Dubey, N.K. Essential oils and their bioactive compounds as eco-friendly novel green pesticides for management of storage insect pests: Prospects and retrospects. Environ. Sci. Pollut. Res. 2021, 28, 18918–18940. [Google Scholar] [CrossRef] [PubMed]
- James, D.G.; Price, T.S. Field-testing of methyl salicylate for recruitment and retention of beneficial insects in grapes and hops. J. Chem. Ecol. 2004, 30, 1613–1628. [Google Scholar] [CrossRef] [PubMed]
- Li, X.; Zhang, L.P.; Zhang, L.; Yan, P.; Ahammed, G.J.; Han, W.Y. Methyl salicylate enhances flavonoid biosynthesis in tea leaves by stimulating the phenylpropanoid pathway. Molecules 2019, 24, 362. [Google Scholar] [CrossRef]
- Lee, M.; Dey, K.P.; Lee, Y.S. Complexation of methyl salicylate with β-cyclodextrin and its release characteristics for active food packaging. Food Sci. Biotechnol. 2020, 29, 917–925. [Google Scholar] [CrossRef]
- Ren, Y.; Wang, W.; He, J.; Zhang, L.; Wei, Y.; Yang, M. Nitric oxide alleviates salt stress in seed germination and early seedling growth of pakchoi (Brassica chinensis L.) by enhancing physiological and biochemical parameters. Ecotoxicol. Environ. Saf. 2020, 187, 109785. [Google Scholar] [CrossRef]
- Khaliq, G.; Ullah, M.; Memon, S.A.; Ali, A.; Rashid, M. Exogenous nitric oxide reduces postharvest anthracnose disease and maintains quality of custard apple (Annona squamosa L.) fruit during ripening. J. Food Meas. Charact. 2021, 15, 707–716. [Google Scholar] [CrossRef]
- Singh, S.P.; Singh, Z.; Swinny, E.E. Postharvest nitric oxide fumigation delays fruit ripening and alleviates chilling injury during cold storage of Japanese plums (Prunus salicina Lindell). Postharvest Biol. Technol. 2009, 53, 101–108. [Google Scholar] [CrossRef]
- Lai, T.F.; Wang, Y.Y.; Li, B.Q.; Qin, G.Z.; Tian, S.P. Defense responses of tomato fruit to exogenous nitric oxide during postharvest storage. Postharvest Biol. Technol. 2011, 62, 127–132. [Google Scholar] [CrossRef]
- Lata, D.; Aftab, M.A.; Homa, F.; Ahmad, M.S.; Siddiqui, M.W. Effect of eco-safe compounds on postharvest quality preservation of papaya (Carica papaya L.). Acta Physiol. Plant. 2018, 40, 8. [Google Scholar] [CrossRef]
- Zhou, Y.H.; Li, S.M.; Zeng, K.F. Exogenous nitric oxide-induced postharvest disease resistance in citrus fruit to Colletotrichum gloeosporioides. J. Sci. Food Agric. 2016, 96, 505–512. [Google Scholar] [CrossRef] [PubMed]
- Ren, Y.; Yan, T.; Hu, C.; Liu, D.; He, J. Exogenous nitric oxide-induced postharvest gray spot disease resistance in Loquat fruit and its possible mechanism of action. Int. J. Mol. Sci. 2023, 24, 4369. [Google Scholar] [CrossRef] [PubMed]
- Mahajan, P.V.; Caleb, O.J.; Singh, Z.; Watkins, C.B.; Geyer, M. Postharvest treatments of fresh produce. Philos. Trans. A Math. Phys. Eng. Sci. 2014, 372, 20130309. [Google Scholar] [CrossRef] [PubMed]
- Zaharah, S.S.; Singh, Z. Mode of action of nitric oxide in inhibiting ethylene biosynthesis and fruit softening during ripening and cool storage of ‘Kensington Pride’ mango. Postharvest. Biol. Technol. 2011, 62, 258–266. [Google Scholar] [CrossRef]
- Soegiarto, L.; Wills, R.B.H. Short term fumigation with nitric oxide gas in air to extend the postharvest life of broccoli, green bean, and bok choy. Hortic. Tech. 2004, 14, 538–540. [Google Scholar] [CrossRef]
- Ma, Y.; Fu, L.; Hussain, Z.; Huang, D.; Zhu, S. Enhancement of storability and antioxidant systems of sweet cherry fruit by nitric oxide-releasing chitosan nanoparticles (GSNO-CS NPs). Food Chem. 2019, 285, 10–21. [Google Scholar] [CrossRef]
- Lo’ay, A.A.; Taher, M.A. Influence of edible coatings chitosan/PVP blending with salicylic acid on biochemical fruit skin browning incidence and shelf life of guava fruits cv. ‘Banati’. Sci. Hortic. 2018, 235, 424–436. [Google Scholar] [CrossRef]
- Carvalho, J.D.L.M.; Gomes, P.B.; Godoy, R.L.O.; Pacheco, S.; Fernandes do Monte, P.H.; de Carvalho, J.L.V.; Nutti, M.R.; Neves, A.C.L.; Vieira, A.C.; Ramos, S.R.R. Total carotenoid content, α-carotene and β-carotene, of landrace pumpkins (Cucurbita moschata Duch): A preliminary study. Food Res. Int. 2012, 47, 337–340. [Google Scholar] [CrossRef]
- Zhang, Z.; Huber, D.J.; Qu, H.; Yun, Z.; Wang, H.; Huang, Z.; Huang, H.; Jiang, Y. Enzymatic browning and antioxidant activities in harvested litchi fruit as influenced by apple polyphenols. Food Chem. 2015, 171, 191–199. [Google Scholar] [CrossRef]
- Elsherbiny, A.E.; Dawood, H.D.; Elsebai, M.F.; Mira, A.; Taher, M.A. Control of dry rot and resistance induction in potato tubers against Fusarium sambucinum using red onion peel extract. Postharvest Biol. Technol. 2023, 195, 112119. [Google Scholar] [CrossRef]
- Luo, Z.; Xu, X.; Yan, B. Accumulation of lignin and involvement of enzymes in bamboo shoot during storage. Eur. Food Res. Technol. 2008, 226, 635–640. [Google Scholar] [CrossRef]
- Lowry, O.H.; Rosebrough, N.J.; Farr, A.L.; Randall, R.J. Protein measurement with the Folin phenol reagent. J. Biol. Chem. 1951, 193, 265–275. [Google Scholar] [CrossRef]
- Assis, J.S.; Maldonado, R.; Munoz, T.; Escribano, M.I.; Merodio, C. Effect of high carbon dioxide concentration on PAL activity and phenolic contents in ripening Cherimoya fruit. Postharvest Biol. Technol. 2001, 23, 33–39. [Google Scholar] [CrossRef]
- Rubilar, J.F.; Cruz, R.M.; Silva, H.D.; Vicente, A.A.; Khmelinskii, I.; Vieira, M.C. Physico-mechanical properties of chitosan films with carvacrol and grape seed extract. J. Food Eng. 2013, 115, 466–474. [Google Scholar] [CrossRef]
- Tantala, J.; Rachtanapun, C.; Tongdeesoontorn, W.; Jantanasakulwong, K.; Rachtanapun, P. Moisture sorption isotherms and prediction models of carboxymethyl chitosan films from different sources with various plasticizers. Adv. Mater. Sci. Eng. 2019, 2019, 4082439. [Google Scholar] [CrossRef]
- Bashir, M.; Haripriya, S. Assessment of physical and structural characteristics of almond gum. Int. J. Biol. Macromol. 2016, 93, 476–482. [Google Scholar] [CrossRef]
- Marzano, M.; Borbone, N.; Amato, F.; Oliviero, G.; Fucile, P.; Russo, T.; Sannino, F. 3D chitosan-gallic acid complexes: Assessment of the chemical and biological properties. Gels 2022, 8, 124. [Google Scholar] [CrossRef]
- Paliani, G.; Poletti, A.; Santucci, A. Vibrational spectrum of sodium nitroprusside. Normal coordinateanalysis for the Fe(CN)5NO2− ion. J. Mol. Struct. 1971, 8, 63–74. [Google Scholar] [CrossRef]
- Liu, L.; Ma, Z.; Xie, L.; Wang, X.; Wang, W.; Wang, H. Spectrometric studies on sodium nitroprusside and its interaction with HSA upon photoirradiation. Int. J. Exp. Spectroscopic. Tech. 2018, 3, 21. [Google Scholar] [CrossRef] [PubMed]
- Do Carmo, D.R.; Souza, M.M.; Bicalho, U.O.; Dos Santos, V.S.; Souza, J.P.; Silvestrini, D.R. Direct preparation and characterization of copper pentacyanonitrosylferrate nanoparticles. J. Nanomater. 2015, 2015, 502424. [Google Scholar] [CrossRef]
- Parimoo, P.; Bharathi, A.; Mamatha, D. Hydrogen bonding studies in menthol and methyl salicylate in drug formulations by vibrational spectroscopy. Asian J. Chem. 1996, 8, 247–254. [Google Scholar]
- Mendes, S.; Catarino, A.; Zille, A.; Fernandes, N.; Bezerra, F.M. Vehiculation of methyl salicylate from microcapsules supported on textile matrix. Materials 2021, 14, 1087. [Google Scholar] [CrossRef] [PubMed]
- Espinosa-Andrews, H.; Sandoval-Castilla, O.; Vázquez-Torres, H.; Vernon-Carter, E.J.; Lobato-Calleros, C. Determination of the gum Arabic–chitosan interactions by Fourier transform infrared spectroscopy and characterization of the microstructure and rheological features of their coacervates. Carbohydr. Polym. 2010, 79, 541–546. [Google Scholar] [CrossRef]
- Cholmaitri, C.; Uthairatanakij, A.; Laohakunjit, N.; Jitareerat, P.; Mingvanish, W. Controlled release of methyl salicylate by biosorbents delays the ripening of banana fruit. Peer J. Mater. Sci. 2020, 2, e12. [Google Scholar] [CrossRef]
- Silveira, N.M.; Prataviera, P.J.C.; Pieretti, J.C.; Seabra, A.B.; Almeida, R.L.; Machado, E.C.; Ribeiro, V.R. Chitosan-encapsulated nitric oxide donors enhance physiological recovery of sugarcane plants after water deficit. Environ. Exp. Bot. 2021, 190, 104593. [Google Scholar] [CrossRef]
- Verlee, A.; Mincke, S.; Stevens, C.V. Recent developments in antibacterial and antifungal chitosan and its derivatives. Carbohydr. Polym. 2017, 164, 268–283. [Google Scholar] [CrossRef]
- Zhang, N.; Ji, N.; Liu, R.; Wang, R.; Chen, C.; Ma, C.; Nie, H.; Lei, J.; Tao, Q. Effects of pre-harvest spraying with salicylic acid (SA) and sodium nitroprusside (SNP) on storage quality and pathogenic fungal species in ‘Manaohong’ cherries. Agronomy 2023, 13, 2853. [Google Scholar] [CrossRef]
- Filho, S.P.M.; Andrade, A.L.; Lopes, J.B.A.C.; Pinheiro, A.A.; de Vasconcelos, M.A.; Fonseca, S.G.D.C.; Lopes, L.G.F.; Sousa, E.H.S.; Teixeira, E.H.; Longhinotti, E. The biofilm inhibition activity of a NO donor nanosilica with enhanced antibiotics action. Int. J. Pharm. 2021, 610, 121220. [Google Scholar] [CrossRef] [PubMed]
- Zhang, Z.Z.; Li, Y.B.; Qi, L.; Wan, X.C. Antifungal activities of major tea leaf volatile constituents toward Colletorichum camelliae Massea. J. Agric. Food Chem. 2006, 54, 3936–3940. [Google Scholar] [CrossRef]
- Verdi, C.M.; Machado, V.S.; Machado, A.K.; Klein, B.; Bonez, P.C.; de Andrade, E.N.C.; Rossi, G.; Campos, M.M.; Wagner, R.; Sagrillo, M.R.; et al. Phytochemical characterization, genotoxicity, cytotoxicity, and antimicrobial activity of Gautheria procumbens essential oil. Nat. Prod. Res. 2022, 36, 1327–1331. [Google Scholar] [CrossRef]
- Lin, Y.; Qasim, M.; Hussain, M.; Akutse, K.; Avery, P.; Dash, C.; Wang, L. The herbivore-induced plant volatiles methyl salicylate and menthol positively affect growth and pathogenicity of entomopathogenic fungi. Sci. Rep. 2017, 7, 40494. [Google Scholar] [CrossRef] [PubMed]
- Wang, L.; Hu, W.; Deng, J.; Liu, X.; Zhou, J.; Li, X. Antibacterial activity of Litsea cubeba essential oil and its mechanism against Botrytis cinerea. RSC Adv. 2019, 9, 28987–28995. [Google Scholar] [CrossRef]
- Yang, Q.; Wang, J.; Zhang, P.; Xie, S.; Yuan, X.; Hou, X.; Yan, N.; Fang, Y.; Du, Y. In vitro and in vivo antifungal activity and preliminary mechanism of cembratrien-diols against Botrytis cinerea. Ind. Crops Prod. 2020, 154, 112745. [Google Scholar] [CrossRef]
- Kong, H.; Fu, X.; Chang, X.; Ding, Z.; Yu, Y.; Xu, H.; Wang, R.; Shan, Y.; Ding, S. The ester derivatives of ferulic acid exhibit strong inhibitory effect on the growth of Alternaria alternata in vitro and in vivo. Postharvest Biol. Technol. 2023, 196, 112158. [Google Scholar] [CrossRef]
- Ali, A.; Maqbool, M.; Ramachandran, S.; Alderson, P.G. Gum Arabic as a novel edible coating for enhancing shelf-life and improving postharvest quality of tomato (Solanum lycopersicum L.) fruit. Postharvest. Biol. Technol. 2010, 58, 42–47. [Google Scholar] [CrossRef]
- Giménez, M.J.; Valverde, J.M.; Valero, D.; Zapata, P.J.; Castillo, S.; Serrano, M. Postharvest methyl salicylate treatments delay ripening and maintain quality attributes and antioxidant compounds of ‘Early Lory’ sweet cherry. Postharvest. Biol. Technol. 2016, 117, 102–109. [Google Scholar] [CrossRef]
- Ding, C.K.; Wang, C.Y. The dual effects of methyl salicylate on ripening and expression of ethylene biosynthetic genes in tomato fruit. Plant Sci. 2003, 164, 589–596. [Google Scholar] [CrossRef]
- Nkolisa, N.; Magwaza, L.S.; Workneh, T.S.; Chimphango, A. Evaluating evaporative cooling system as an energy-free and cost-effective method for postharvest storage of tomatoes (Solanum lycopersicum L.) for smallholder farmers. Sci. Hortic. 2018, 241, 131–143. [Google Scholar] [CrossRef]
- Meena, M.; Pilania, S.; Pal, A.; Mandhania, S.; Bhushan, B.; Kumar, S.; Gohari, G.; Saharan, V. Cu-chitosan nano-net improves keeping quality of tomato by modulating physio-biochemical responses. Sci. Rep. 2020, 10, 21914. [Google Scholar] [CrossRef] [PubMed]
- Soleimanie, S.A.; Vafaee, Y.; Saba, M.K. Preharvest application of sodium nitroprusside improves tomato fruit quality and alleviates chilling injury during cold storage. Int. J. Veg. Sci. 2020, 26, 364–378. [Google Scholar] [CrossRef]
- Giuliano, G.; Bartley, G.E.; Scolnik, P.A. Regulation of carotenoid biosynthesis during tomato development. Plant. Cell 1993, 5, 379–387. [Google Scholar] [PubMed]
- Chrysargyris, A.; Nikou, A.; Tzortzakis, N. Effectiveness of Aloe vera gel coating for maintaining tomato fruit quality. N. Z. J. Crop Hortic. Sci. 2016, 44, 203–217. [Google Scholar] [CrossRef]
- Naeem, A.; Abbas, T.; Ali, T.M.; Hasnain, A. Effect of antioxidant and antibacterial properties of guar gum coating containing spice extracts and its application on tomatoes (Solanum lycopersicum L.). J. Food Meas. Charact. 2018, 12, 2725–2734. [Google Scholar] [CrossRef]
- Zewdie, B.; Shonte, T.T.; Woldetsadik, K. Shelf life and quality of tomato (Lycopersicon esculentum Mill.) fruits as affected by neem leaf extract dipping and beeswax coating. Int. J. Food Prop. 2022, 25, 570–592. [Google Scholar] [CrossRef]
- Oloyede, G.K. Toxicity, antimicrobial and antioxidant activities of methyl salicylate dominated essential oils of Laportea aestuans (Gaud). Arab. J. Chem. 2016, 9, S840–S845. [Google Scholar] [CrossRef]
- Lo’ay, A.A.; Taher, M.A. Effectiveness salicylic acid blending in chitosan/PVP biopolymer coating on antioxidant enzyme activities under low storage temperature stress of ‘Banati’ guava fruit. Sci. Hortic. 2018, 238, 343–349. [Google Scholar] [CrossRef]
- Dai, Y.; Xie, H.; Zhao, X.; Zheng, Y. The Effect of sodium nitroprusside treatment on storage ability of fresh-cut potato. Foods 2023, 12, 221. [Google Scholar] [CrossRef]
- Chotikakham, S.; Faiyue, B.; Uthaibutra, J.; Saengnil, K. Exogenous methyl salicylate alleviates senescent spotting by enhancing the activity of antioxidative ascorbate-glutathione cycle in harvested ‘Sucrier’ bananas. Sci. Hortic. 2020, 267, 109324. [Google Scholar] [CrossRef]
- Chotikakham, S.; Faiyue, B.; Uthaibutra, J.; Saengnil, K. Effects of methyl salicylate on senescent spotting and hydrogen peroxide concentration in ripening ‘Sucrier’ bananas. Acta Hortic. 2019, 1245, 115–121. [Google Scholar] [CrossRef]
- Petriccione, M.; Mastrobuoni, F.; Pasquariello, M.S.; Zampella, L.; Nobis, E.; Capriolo, G.; Scortichini, M. Effect of chitosan coating on the postharvest quality and antioxidant enzyme system response of strawberry fruit during cold storage. Foods 2015, 4, 501–523. [Google Scholar] [CrossRef] [PubMed]
- Elsherbiny, E.A.; Taher, M.A.; Elsebai, M.F. Activity of Purpureocillium lilacinum filtrates on biochemical characteristics of Sclerotinia sclerotiorum and induction of defense responses in common bean. Eur. J. Plant Pathol. 2019, 155, 39–52. [Google Scholar] [CrossRef]
- Song, Y.; Hu, C.; Xue, Y.; Gu, J.; He, J.; Ren, Y. 24-epibrassinolide enhances mango resistance to Colletotrichum gloeosporioides via activating multiple defense response. Sci. Hortic. 2022, 303, 111249. [Google Scholar] [CrossRef]
- Li, Y.; Han, L.; Wang, B.; Zhang, J.; Nie, J. Dynamic degradation of penconazole and its effect on antioxidant enzyme activity and malondialdehyde content in apple fruit. Sci. Hortic. 2022, 300, 111053. [Google Scholar] [CrossRef]
- Lacan, D.; Baccou, J.C. High levels of antioxidant enzymes correlate with delayed senescence in nonnetted muskmelon fruits. Planta 1998, 204, 377–382. [Google Scholar] [CrossRef]
- Mur, L.A.J.; Naylor, G.; Warner, S.A.J.; Sugars, J.M.; White, R.F.; Draper, J. Salicylic acid potentiates defense gene expression in tissue exhibiting acquired resistance to pathogen attack. Plant J. 1996, 9, 559–571. [Google Scholar] [CrossRef]
- Baninaiem, E.; Dastjerdi, A.M. Enhancement of storage life and maintenance of quality in tomato fruits by preharvest salicylic acid treatment. Front. Sustain. Food Syst. 2023, 7, 1180243. [Google Scholar] [CrossRef]
- Li, C.; Tao, J.; Wu, Z. Gaseous ozone regulates reactive oxygen species metabolism and ascorbate-glutathione cycle to delay the senescence of fresh-cut red pitaya (Selenicereus undatus) fruit. Sci. Hortic. 2023, 312, 111839. [Google Scholar] [CrossRef]

Disclaimer/Publisher’s Note: The statements, opinions and data contained in all publications are solely those of the individual author(s) and contributor(s) and not of MDPI and/or the editor(s). MDPI and/or the editor(s) disclaim responsibility for any injury to people or property resulting from any ideas, methods, instructions or products referred to in the content. |
© 2024 by the authors. Licensee MDPI, Basel, Switzerland. This article is an open access article distributed under the terms and conditions of the Creative Commons Attribution (CC BY) license (https://creativecommons.org/licenses/by/4.0/).
Share and Cite
Taher, M.A.; Dawood, D.H.; Selim, M.A.E.; Amin, B.H.; Elsherbiny, E.A. Effect of Chitosan/Gum Arabic Blends Enriched by Sodium Nitroprusside or Methyl Salicylate on the Storability and Antioxidant Activity of Tomato Fruit. Polymers 2024, 16, 1518. https://doi.org/10.3390/polym16111518
Taher MA, Dawood DH, Selim MAE, Amin BH, Elsherbiny EA. Effect of Chitosan/Gum Arabic Blends Enriched by Sodium Nitroprusside or Methyl Salicylate on the Storability and Antioxidant Activity of Tomato Fruit. Polymers. 2024; 16(11):1518. https://doi.org/10.3390/polym16111518
Chicago/Turabian StyleTaher, Mohamed A., Dawood H. Dawood, Mohammed A. E. Selim, Basma H. Amin, and Elsherbiny A. Elsherbiny. 2024. "Effect of Chitosan/Gum Arabic Blends Enriched by Sodium Nitroprusside or Methyl Salicylate on the Storability and Antioxidant Activity of Tomato Fruit" Polymers 16, no. 11: 1518. https://doi.org/10.3390/polym16111518
APA StyleTaher, M. A., Dawood, D. H., Selim, M. A. E., Amin, B. H., & Elsherbiny, E. A. (2024). Effect of Chitosan/Gum Arabic Blends Enriched by Sodium Nitroprusside or Methyl Salicylate on the Storability and Antioxidant Activity of Tomato Fruit. Polymers, 16(11), 1518. https://doi.org/10.3390/polym16111518

